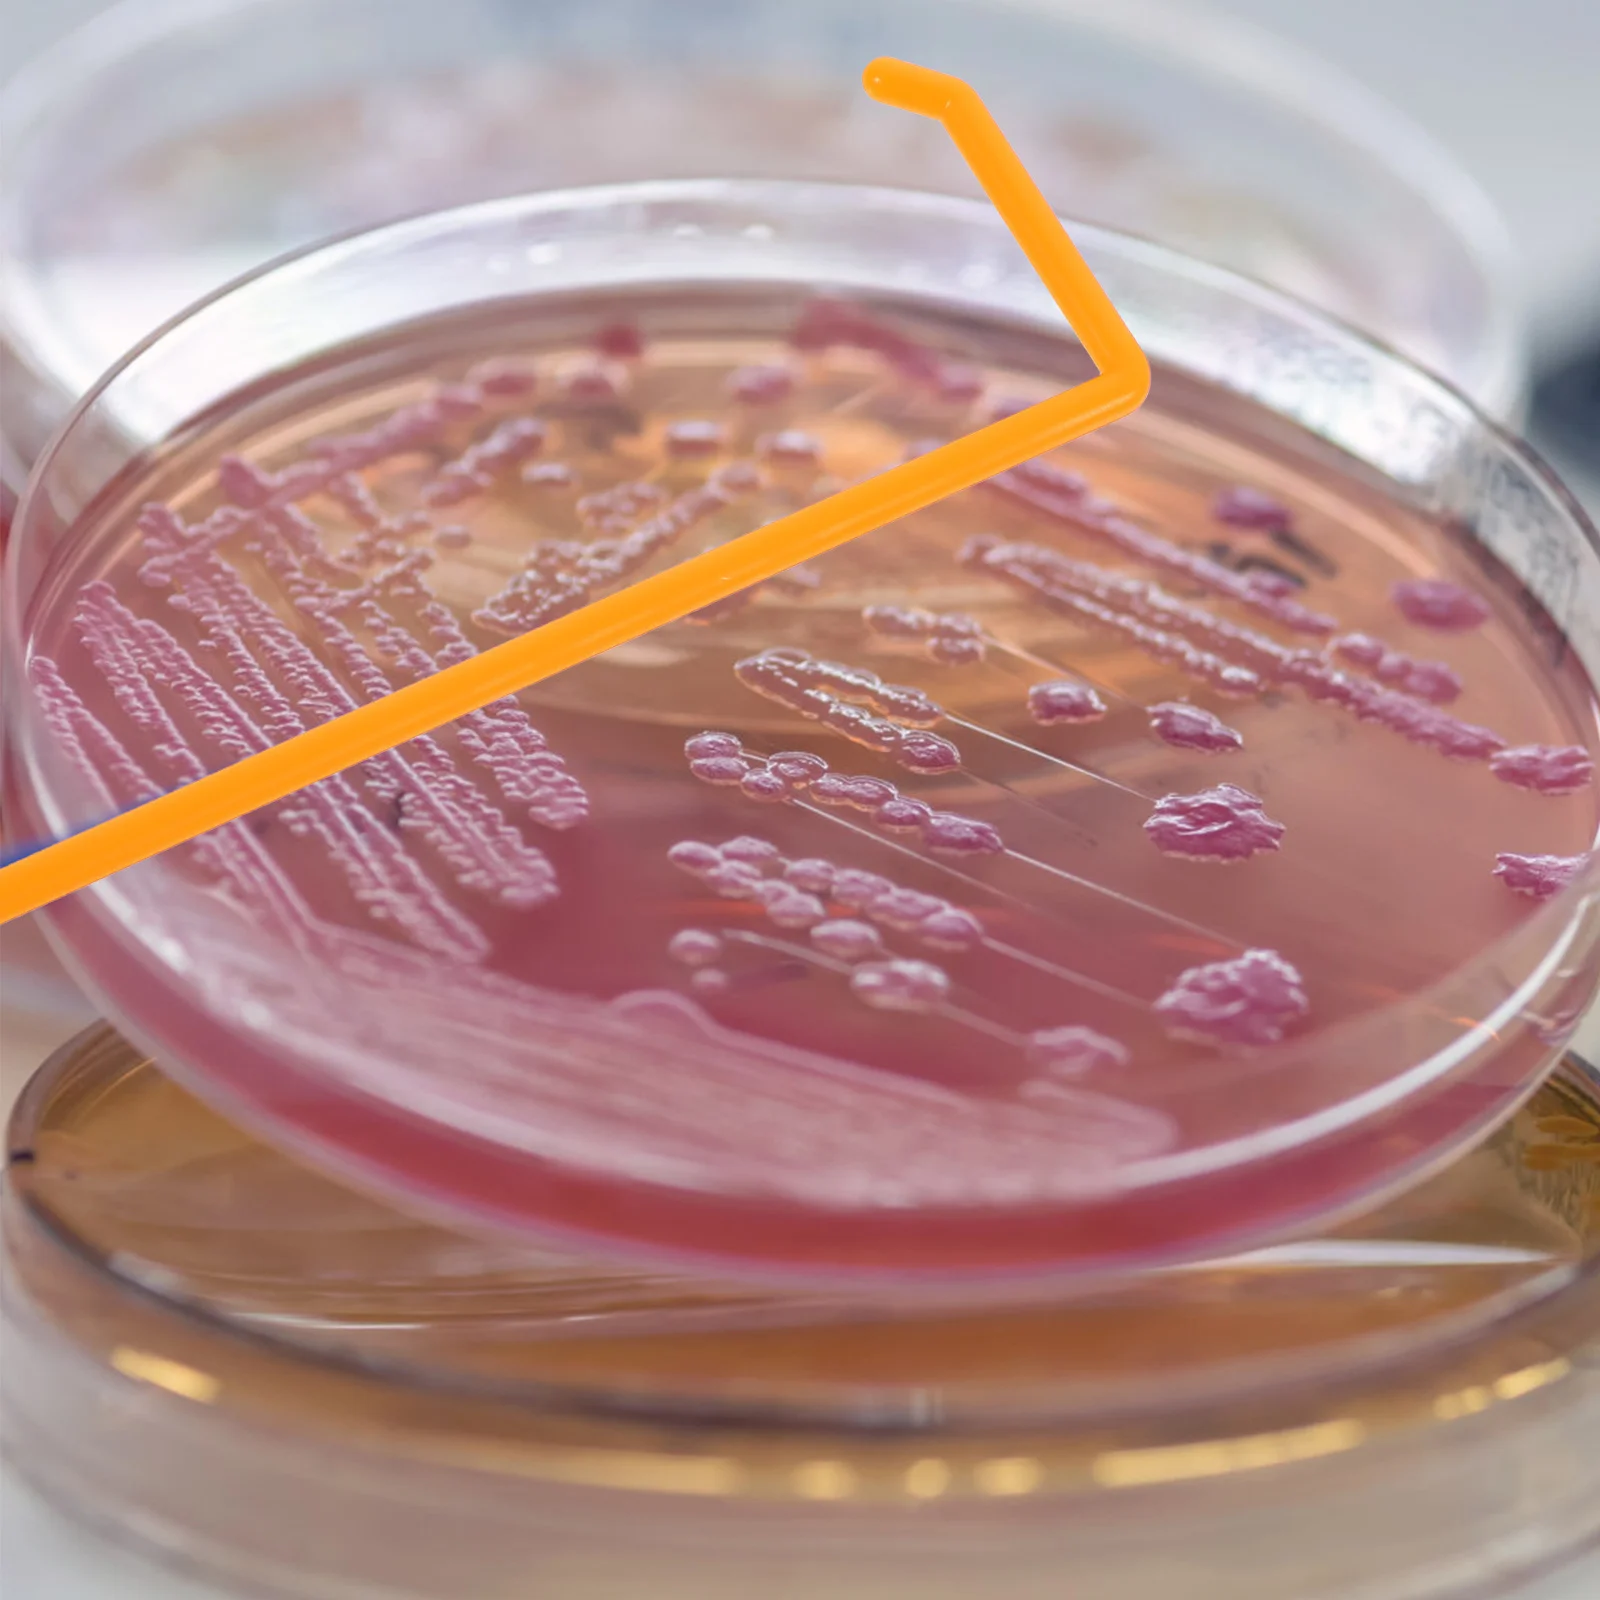

Нечиста сила та iншi капоснi iсторiї | Іван Андрусяк


Наш Формат
sku: 290262003
ACCORDING TO OUR RECORDS THIS PRODUCT IS NOT AVAILABLE NOW
120.00 грн.
Shipping from: Ukraine
Description
[html]Генії теж були дітьми, діти теж будуть геніями. Тематика Література для дітей, 10+, пригоди, історія. Про книжку «Нечиста сила та інші капосні історії» Івана Андрусяка Навіщо потрібні «погані слова»? Як можна і як не можна карати дитину за скоєну шкоду? Чи був юний Тарас Шевченко чемним хлопчиком, — а чи, може, геніальним розбишакою? Чому з Григорієм Сковородою спілкуватися страшно, а з художником-партизаном Нілом Хасевичем — ні? Яким би був чи була ти, якби довелося жити не в наш час, а п'ятдесят, сто, двісті років тому? Для кого книжка Для молодших підлітків, 10+, які полюбляють короткі влучні пригодницькі твори як на сучасні, так і на історичні теми; а також для батьків, які прагнуть, щоб їхні діти росли свідомими й мислячими особистостями. Чому варто прочитати книгу «Нечиста сила та інші капосні історії» Автор оповідає про нібито звичайних дітей і підлітків – таких, як ти. І виявляється, що насправді всі вони – незвичайні! Звісно, ми знаємо, що з кмітливого розбишаки Тараса, який так хвацько й весело лякає своїх односельців «нечистою силою», згодом виросте геніальний Шевченко. А із замріяного волинського хлопчика, який найдужче любить малювати і купатися в річці – славетний художник-повстанець Ніл Хасевич, завдяки якому світ дізнається про подвиги УПА. Та поряд із ними – сучасні герої «розбишацьких оповідань». Поряд із ними – ти! Такий само незвичайний, якими в дитинстві й у підлітковому віці були генії! Ким виростеш ти? Про автора Іван Андрусяк – один із найвідоміших сучасних українських дитячих письменників, автор Чакалки, Бурундука, Дибайла та багатьох інших популярних персонажів. Лауреат Премії Лесі Українки (2019). 2013 року повість «Вісім днів із життя Бурундука» увійшла до престижного щорічного каталогу найкращих дитячих книжок світу «White Ravens». Керівник Дитячої редакції «Нашого Формату». Ілюстрації зробила Марія Савко – молода львівська художниця, цьогорічна випускниця Львівської національної академії мистецтв. «Нечиста сила та інші капосні історії» – дебютна книжка талановитої ілюстраторки. Книжки, схожі за тематикою «Загублені в таборі» Настя Музиченко, «Наш Формат», 2020 рік «Швидше не буває» Сергій Пантюк, «Наш Формат», 2020 рік Інші книжки Івана Андрусяка «Сірка на порох» Іван Андрусяк, «Фонтан казок», 2020 рік «Морськосвинський детектив» Іван Андрусяк, «Віват», 2020 рік ВідгукХудожні твори, у яких завдяки багатій уяві Івана Андрусяка виходять на очі читача живі і зовсім не хрестоматійно-зашорені постаті українських геніїв, дають нове бачення відомих митців, розкривають їх у незвичному ракурсі. Ольга Новик, доктор філологічних наук, професор[/html]
Technical Details
| categoryTitle: | Литература |
| label: | Сделано в Украине |
Price history chart & currency exchange rate
Customers also viewed

4,180.76 грн.
Dresser for Bedroom, Black Dresser with LED, 6 Drawers Dresser with Large Organizer, Wood Dressers & Chests of Drawers
aliexpress.com
4,282.97 грн.
YYHC 1080P Wireless PTZ CCTV Speed Dome Solar IP Camera Wifi for Home Outdoor
aliexpress.com
1,044.98 грн.
For Nissan Pulsar C13 2014~2018 Europe Model Windscreen Windshield Accessories Window 2014 2015 2016 2017 Car Front Wiper Blades
aliexpress.com
557.60 грн.
4PCS304 stainless steel needle roller bearing copper wheel old-fashioned plastic steel window pulley sliding window track roller
aliexpress.com
594.17 грн.
Hardware Lock, Bathroom Bathroom Door Lock, Aluminum Alloy Swing Door Handle, Glass Sliding Door Lock
aliexpress.com
451.23 грн.
mahihkan- Wolf Throw Pillow Christmas Covers covers for pillows Sofa Cushion Cover Luxury Cushion Cover
aliexpress.com
767.01 грн.
Motorcycle Regulator Rectifier For Honda CT125A AC C125A 2AC 2021-2023 MSX125 GROM125/ GROM125A AC 2022-2024
aliexpress.com
85.59 грн.
9.2cm 13.6g Frog Type Topwater Lure Silicone Double Propeller Soft Bait Artificial Wobbler Thunder Fishing Lure Fishing Tools
aliexpress.com
61,120.47 грн.
4040 co2 Лазерная режущая машина для гравировки керамики, стекла и других неметаллических материалов
aliexpress.ru
2,880.66 грн.
Jumper T-Lite V2 2.4Ghz 16CH Hall Sensor Gimbals Built-In JP4IN1 Multi-Protocol Opentx Transmitter For RC Drone Airplane Parts
aliexpress.com
4,150.85 грн.
WY720 Solder Station Electric Solder Iron LED Digital Display Rework Station With Soldering Tips Welding Tool EU Plug
aliexpress.com
2,333.86 грн.
Custom 24styles Halloween Makeup Puff Pumpkin Ghost Face Soft Foundation Sponges Powder Puff Women Make Up Accessories Bulk
aliexpress.com
324.51 грн.
Gesang Flower Garland Bohemian Hairband Cloth Flower Hair Hoop Lace-up Headwear for Valentine's Day Christmas Gift
aliexpress.com
986.81 грн.
Круглая машина для резки образцов ткани для тестирования веса текстильной ткани
aliexpress.ru
5,546.93 грн.
Free shipping SKWoptics riflescopes 1.25-5x26 XMOA-G Tactical with side mount Hunting AK sight MOA reticle
aliexpress.com
730.86 грн.
CURREN Fashion Creative Design Watch Men Quartz Stainless Steel Date Wristwatches for Male Luminous Clock
aliexpress.com
1,090.27 грн.
FGO Ereshkigal Cosplay Fate Grand Order Ereshkigal Cosplay Shoes High Heel Golden Boots Custom Made
aliexpress.com
1,232.79 грн.
Modern Japan Style Led Oak wooden Wall Lamps Lights Bedroom Bed lamp bathroom Home Wall Sconce solid wood wall light fixtures
aliexpress.com
353.59 грн.
Simple Leggings Women Solid High Elasticity Slender Jogging Soft Breathable Teenagers Workout All-match Fashion Fitness Leisure
aliexpress.com
304.56 грн.
2022 new hot summer Children shorts boy girl child Harem Dinosaur Pants loose army kids clothes toddler baby sports clothing
aliexpress.com
380.18 грн.
Bicycle Dustproof Cycling Shoe Cover for Men Women Thickening Warm Bike Shoe Cover Windproof MTB Bicycle Overshoes Riding Boots
aliexpress.com
177.83 грн.
New 7 inch replacement FPC-FC70S706-01 touch screen handwriting screen capacitive screen Free shipping
aliexpress.com
3,173.21 грн.
Наушники Bluetooth Sound Quality Enhancement Ear Cuff Wireless Ears Open Ear Sound Leak Control Bone Conduction Earphones That Do Not
joom.com
284.58 грн.
Краска для сколов KIWIX OPEL/VAUXHALL 18 NORDIC BLUE 20 мл/18-039980K, Синий, OPEL/VAUXHALL 18 NORDIC BLUE 20 мл
goods.ru
203.18 грн.
Новые карты Tarot, терминал, настольная игра, гадания, игра Destiny Premium Card, полный английский PDF инструкция
aliexpress.ru